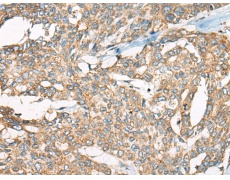
一抗

中文名稱:兔抗YEATS2多克隆抗體
|
Background: |
YEATS2 is a scaffolding subunit of the ADA2A (TADA2A; MIM 602276)-containing (ATAC) histone acetyltransferase complex (Wang et al., 2008 |
|
Applications: |
WB, IHC |
|
Name of antibody: |
YEATS2 |
|
Immunogen: |
Synthesized peptide derived from internal of human YEATS2. |
|
Full name: |
YEATS domain containing 2 |
|
Synonyms: |
0 |
|
SwissProt: |
Q9ULM3 |
|
IHC positive control: |
Human breast carcinoma tissue |
|
IHC Recommend dilution: |
50-100 |
|
WB Predicted band size: |
151 kDa |
|
WB Positive control: |
293 cells lysate |
|
WB Recommended dilution: |
500-3000 |

 購物車
購物車 幫助
幫助
 021-54845833/15800441009
021-54845833/15800441009